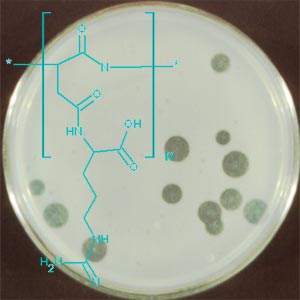

Cyanophycin - Biosynthese und Abbau
Cyanophycin-Synthetase
![]() | ![]() |
Abb. 1 Cyanophycin Strukturmodelle | |
Das gereinigte Polymer besteht aus äquimolaren Mengen an Arginin und Asparaginsäure, die über α- und β-Amidbindungen verknüpft sind. Variationen in der Aminosäurezusammensetzung sind gefunden worden.
Die Polymerisierung von Aspartat und Arginin und damit die Biosynthese von Cyanophycin wird von einem einzigen Enzym katalysiert, der Cyanophycin-Synthetase (CphA).
| Arg | Arg | |
| (Asp)n + Asp + Arg + 2 ATP | -> | (Asp)n+1 + 2 ADP + 2 Pi |
Abb. 2 Cyanophycin-Synthetase katalysierte Reaktion | ||
Cyanophycin-Synthetasen unterschiedlicher Herkunft sind gereinigt und charakterisiert worden. Das Enzym besteht aus zwei identischen Untereinheiten von jeweils 90 bis 130 kDa.
Sequenzanalysen der Translationsprodukte von cphA ergaben hohe Ähnlichkeiten innerhalb der Cyanophycin-Synthetasen unterschiedlicher Herkunft und erbrachten darüber hinaus Übereinstimmungen zu ATP-abhängigen Ligasen.
Aktuelle Ziele
- Biochemie des Schlüsselenzyms. Die biochemischen Eigenschaften und der Cyanophycin-Synthese werden weiterhin untersucht, um zu einer exakten Beschreibung des Katalysemechanismus zu kommen.
- In vitro Synthese von Cyanophycin. Die aus dem thermophilen Synechococcus sp. Stamm MA19 gereinigte Cyanophycin-Synthetase weist eine bemerkenswerte Stabilität auf, was dieses Enzym zu einem Kandidaten für die Entwicklung eines in vitro-Prozesses zur Produktion von Cyanophycin im Gramm-Maßstab macht.
- Mikrobielle Produktion von Polyasparaginsäure und Cyanophycin-ähnlichen Polyamiden mit modifizierten Enzymen. Durch Einsatz ungerichteter und gerichteter Mutagenesen werden modifizierte Cyanophycin-Synthetasen erzeugt, die in ihrer Fähigkeit zum Einbau von Arginin gestört sind und somit Polyasparaginsäure oder Cyanophycin-ähnliche Polyamide mit geänderten Seitengruppen synthetisieren.
Produktion von Cyanophycin
Cyanobakterien sind aus vielerlei Gründen (u. a. geringe Ausbeuten) keine geeigneten Produktionsorganismen für Cyanophycin. Dagegen akkumuliert ein Stamm des chemotrophen Cyanophycin-Bildners A. calcoaceticus bis zu 40 % an der Zelltrockenmasse. Darüber hinaus wurden cphA-Gene aus Cyanobakterien in industriell relvanten, heterotrophen Bakterien exprimiert (Escherichia coli, Corynebacterium glutamicum, Ralstonia eutropha, Pseudomonas putida). Durch "Metabolic Engineering" mit Hilfe von Genausschaltung und Geneinführung wurden die Stämme optimiert, um den Metabolitenfluß in Richtung Cyanophycin zu steigern. Ein Verfahren zur Isolierung von Cyanophycin im technischen Maßstab wurde entwickelt.![]() |
Aktuelle Ziele
- Produktion von Cyanophycin im Pilot-Maßstab. Der gegenwärtige Einsatz unterschiedlicher rekombinanter Bakterienstämme zur Herstellung von Cyanophycin im Kulturvolumen von 500 l wird ständig optimiert, um einen effektiven Prozess zu realisier.
- Charakterisierung von Cyanophycin. In Zusammenarbeit mit Partnern aus der Wissenschaft und der Industrie werden die physikalischen und Materialeigenschaften von Cyanophycin festgestellt.
- Chemische Modifizierung von Cyanophycin. Aufgrund der reaktiven Guanidinogruppe der Arginylseitenketten können elektrophile Reagenzien an das Polymer gekoppelt werden, was zu neuen Polymeren mit neuen Eigenschaften führen wird.
Abbau von Cyanophycin
Während die Biosynthese von Cyanophycin seit seiner Entdeckung (1887) bereits sehr intensiv untersucht worden ist, sind bislang nur wenige Untersuchungen zur Erforschung des biologischen Abbaus dieser Polyaminosäure durchgeführt worden. Eine Suche nach Cyanophycin-abbauenden Mikroorganismen führte zur Identifizierung und Charakterisierung von zahlreichen aeroben Gram-negativen sowie Gram-positiven Bakterienstämmen. Zudem konnten vor kurzem fakultativ und strikt anaerobe Bakterien isoliert werden, die fähig sind, Cyanophycin als alleinige Kohlenstoff- und Stickstoffquelle zu nutzen.![]() |
Abb. 4 Klärhofbildung durch aerobe Cyanophycin-abbauende Bakterien |
Eine extrazelluläre Cyanophycinase aus Pseudomonas anguilliseptica BI wurde gereinigt und durch eingehende biochemische Charakterisierung wurden Abbauprodukte und katalytischer Mechanismus der Abbaureaktion bestimmt, sowie das Strukturgen cphEPa kloniert. Auch die Cyanophycinase des Gram-positiven Stammes Bacillus megaterium BAC19 (CphEBm) wurde in ähnlicher Weise charakterisiert. Weiterhin wurden enzymkinetische Analysen der Cyanophycinase-Reaktionen von P. anguilliseptica BI und B. megaterium BAC19 durchgeführt.
Darüber hinaus werden zurzeit Cyanophycin-Abbauexperimente mit anaeroben Bakterien, sowie Bakterien mit anderen hydrolytischen Abbauenzymen wie Asparaginasen und mit industriell produzierten Enzymen durchgeführt. Ziel dieser Arbeiten ist die Herstellung der großtechnisch relevanten Polyaminosäure Poly(asparaginsäure) ausgehend von Cyanophycin.
![]() |
Abb. 5 Hydrolytische Abbauwege des Cyanophycins. |
Aktuelle Ziele
- Taxonomische Charakterisierung von Cyanophycin-abbauenden Bakterien. Die kürzlich isolierten anaeroben Bakterien, die zur Hydrolyse von Cyanophycin und zur Verwertung von Polyamiden als alleiniger Kohlenstoff- und Stickstoffquelle befähigt sind, werden taxonomisch und phylogenetisch charakterisiert.
- Isolierung und Charakterisierung von Cyanophycinasen. Die Exoenzyme von Bakterien, die in die Hydrolyse von Cyanophycin involviert sind, werden gereinigt und biochemisch charakterisiert.
- Identifizierung und Klonierung Cyanophycinase-kodierender Gene. Mit Hilfe der N-terminalen Aminosäuresequenzen gereinigter Cyanophycinasen bzw. Expressionsgenbänken werden die Cyanophycinase-kodierenden Gene identifiziert, kloniert und sequenziert.
- Einbeziehung anderer hydroytischer Enzyme. Enzyme, die ähnliche hydrolytische Spaltungen katalysieren wie die gewünschte ß-Spaltung von Cyanophycin werden auf ihre Eignung zur Herstellung von Poly(asparaginsäure) geprüpft bzw. durch Mutagenese in ihrer Substratspezifität verändert, um die gewünschte Hydrolysereaktion durchzuführen.
Stichwörter:
Acinetobacter sp., Anabaena variabilis PCC7120, Bacillus licheniformis, Biologischer Abbau, Biotechnische Produktion, cap Gene, Corynebacterium glutamicum, cphA, cphB, Cyanobakterien, Cyanophycin, Cyanophycinase, Cyanophycin Grana Polypeptid, Cyanophycin-Synthetase, Gülle, Multi-L-Arginyl-Poly-L-Asparaginsäure, Natrialba aegyptiaca, Nostoc ellipsosporum, Polyaminosäuren, Polyasparaginsäure, Polyglutaminsäure, Polyglutaminsäure-Synthetase, Pseudomonas putida, Ralstonia eutropha, Synechococcus elongatus, Synechococcus sp. Stamm MA19, Synechocystis sp. Stamm PCC6308, Synechocystis sp. Stamm PCC6803| Am Projekt beteiligte Mitarbeiter | Koorperationspartner, Förderung, Finanzierung | |
| Zur Zeit: Früher: | Pia Dahm Simone Diniz Yasser Elbahloul Kay Michael Frey Gregor Füser Tran Hai Martin Obst Ahmed Sallam Alexander Steinbüchel Ingo Voß Said Zine Elsayed Aboulmagd Firat Atasoy Francis F. Hezayen Astrid Hoppensack Sabine Jossek Martin Krehenbrink Andreas Krug Fred Bernd Oppermann Markus Pötter Hector M. Alvarez Daniel Mergelkamp Ingo Voss | |
Publikationen
I Publications in peer reviewed journals (original contributions)
- Elbahloul, Y., and A. Steinbüchel. 2006. Engineering the genotype of Acinetobacter sp. strain ADP1 towards enhanced biosynthesis of cyanophycin. Appl. Environ. Microbiol., accepted for publication.
- Diniz, S., I. Voß, and A. Steinbüchel. 2005. Optimization of cyanophycin production in recombinant strains of Pseudomonas putida and Ralstonia eutropha employing elementary mode analysis and statistical experimental design. Biotechnol. Bioeng., accepted for publication.
- Voß, I., and A. Steinbüchel. 2005. Application of a KDPG aldolase gene-dependent addiction system for enhanced production of cyanophycin in Ralstonia eutropha. Metabolic Engineering DOI 10.1016/j.ymben.2005.09.003.
- Elbahloul, Y., K. Frey, J. Sanders, and A. Steinbüchel. 2005. Protamylasse, a residual compound of industrial starch production, provides a suitable medium for large scale cyanophycin production. Appl. Environ. Microbiol. 71:7759-7767.
- Obst, M., H. Luftmann, and A. Steinbüchel. 2005. Degradation of cyanophycin by Sedimentibacter hongkongensis strain K1 and Citrobacter amalonaticus strain G isolated from an anaerobic bacterial consortium. Appl. Environ. Microbiol. 71:3642-3652.
- Füser, G., and A. Steinbüchel. 2005. Investigations on the solubility behaviour of cyanophycin - solubility of cyanophycin in solutions of simple inorganic salts. Biomacromolecules 6:1367-1374.
- Elbahloul, Y., M. Krehenbrink, R. Reichelt, and A. Steinbüchel. 2005. Physiological conditions for high cyanophycin content in biomass of Acinetobacter calcoaceticus strain ADP1. Appl. Environ. Microbiol. 71:858-866.
- Voß, I., S. C. Diniz, E. Aboulmagd, and A. Steinbüchel. 2004. Identification of the Anabaena sp. strain PCC7120 cyanophycin synthetase as suitable enzyme for production of cyanophycin in Gram-negative bacteria like Pseudomonas putida and Ralstonia eutropha. Biomacromolecules 5:1588-1595.
- Krehenbrink, M., and A. Steinbüchel. 2004. Partial purification and characterization of a non-cyanobacterial cyanophycin synthetase from Acinetobacter calcoaceticus strain ADP1 with regard to substrate specificity, substrate affinity and binding to cyanophycin. Microbiology 150:2599-2608.
- Obst, M., A. Sallam, H. Luftmann, and A. Steinbüchel. 2004. Isolation and characterization of Gram-positive cyanophycin degrading bacteria – kinetic studies on cyanophycinase activity in aerobic bacteria. Biomacromolecules 5:153-161
- Hoppensack, A., Oppermann-Sanio, F. B., and A. Steinbüchel. 2003. Conversion of the nitrogen content in liquid manure into biomass and polyglutamic acid by a newly isolated strain of Bacillus licheniformis. FEMS Microbiol. Lett. 218:39-45.
- Obst, M., Oppermann-Sanio, F. B., Luftmann, H., and A. Steinbüchel. 2002. Isolation of cyanophycin-degrading bacteria, cloning and characterization of an extracellular cyanophycinase gene (cphE) from Pseudomonas anguilliseptica strain BI. J. Biol. Chem. 277:25096-25105.
- Frey, K. M., Oppermann-Sanio, F. B., Schmidt, H., and A. Steinbüchel. 2002. Technical-scale production of cyanophycin with recombinant strains of Escherichia coli. Appl. Environ. Microbiol. 68:3377-3384.
- Krehenbrink, M., F. B. Oppermann-Sanio, and A. Steinbüchel. 2002. Evaluation of non-cyanobacterial genome sequences for occurrence of genes encoding proteins homologous to Cyanophycin syntheatase and cloning of an active cyanophycin synthetase from Acinetobacter sp.strain DSM 587. Arch. Microbiol. 177:371-380.
- Hai, T., F. B. Oppermann-Sanio, and A. Steinbüchel. 2002. Molecular characterization of a thermostable cyanophycin synthetase from the thermophilic cyanobacterium Synechococcus sp. strain MA19 and in vitro synthesis of cyanophycin and related polyamides. Appl. Environ. Microbiol. 68:93-101.
- Aboulmagd, E., I. Voß, F. B. Oppermann-Sanio, and A. Steinbüchel. 2001. Heterologous expression of cyanophycin synthetase and cyanophycin synthesis in Pseudomonas putida and the industrial relevant bacteria Corynebacterium glutamicum and Ralstonia eutropha. BioMacromolecules 2:1338-1342.
- Hezayen, F. F., B. H. A. Rehm, B. J. Tindall, and A. Steinbüchel. 2001. Transfer of Natrialba asiatica B1T to Natrialba taiwanensis sp. nov. and Natrialba egyptiaca sp. nov., a novel extremely halophilic, non-pigmented archaeon from Egypt which produces extracellular poly(glutamic acid). Int. J. Syst. Evol. Microbiol. 51:1133-1142.
- Aboulmagd, E., F. B. Oppermann-Sanio, F. B. and A. Steinbüchel. 2001. Purification of the Synechocystis sp. strain PCC6308 cyanophycin synthetase and its characterization with respect to substrate and primer specificity. Appl. Environ. Microbiol. 67:2176-2182.
- Pötter, M., F. B. Oppermann-Sanio, and A. Steinbüchel. 2001. Cultivation of bacteria producing polyamino acids with liquid manures as carbon and nitrogen source. Appl. Environ. Microbiol. 67:617-622.
- Aboulmagd, E., F. B. Oppermann-Sanio and A. Steinbüchel. 2000. Molecular characterization of the cyanophycin synthetase of Synechocystis sp. PCC6308. Arch. Microbiol. 174:297-306.
- Hezayen, F. F., B. H. A. Rehm, R. Eberhardt, and A. Steinbüchel. 2000. Polymer production by two newly isolated extremely halophilic archaea: Application of a novel corrosion-resistant bioreactor. Appl. Microbiol. Biotechnol. 54:319-325.
- Hai, T., H. Ahlers and A. Steinbüchel. 2000. Axenic cultivation of anoxygenic phototrophic bacteria, cyanobacteria and microalgae in a new closed tubular glass photobioreactor. Appl. Microbiol. Biotechnol. 53: 383-389.
- Hai, T., F. B. Oppermann-Sanio, and A. Steinbüchel. 1999. Purification and characterization of cyanophycin and cyanophycin synthetase from the thermophilic Synechococcus sp. MA19. FEMS Microbiol. Lett. 181:229-236.
II Other original contributions
- Pickartz, S., F. B. Oppermann and A. Steinbüchel. 1996. Biodegradation of poly- -glutamic acid. In: DECHEMA Monographs, Vol. 133 (Eds. W. Sand und G. Kreysa), pp. 655-662.
III Review articles in peer reviewed journals or books
- Oppermann-Sanio, and A. Steinbüchel. 2005. Cyanophycin. In: Steinbüchel, A., and Y. Doi (Eds.) Biotechnology of Biopolymers – From Synthesis to Patents. Volume 2, pp. 767-790, WILEY-VCH, Weinheim
- Obst, M., and A. Steinbüchel. 2004. Microbial degradation of poly(amino acid)s. Biomacromolecules 5:1166-1176.
- Oppermann-Sanio, F. B., and A. Steinbüchel. 2003. Cyanophycin. In: S. R. Fahnestock, and A. Steinbüchel (Eds.) Biopolymers, Vol. 7, Wiley-VCH publisher, Weinheim, pp. 83-106.
- Oppermann-Sanio, F. B., and A. Steinbüchel.2002. Occurrence, functions and biosynthesis of polyamides in microorganisms and biotechnological production. Naturwissenschaften 89:11-22.
IV Other review articles
- Oppermann-Sanio, F. B., E. Aboulmagd, T. Hai, F. F. Hezayen, S. Jossek, and A. Steinbüchel. 1998. Biochemistry of microbial polyamide metabolism. In: A. Steinbüchel (Ed.) Proceedings of the international symposium on "Biochemical Principles and Mechanisms of Biosynthesis and Biodegradation of Polymers" in Münster (Germany), June 3 - 6, 1998, Wiley-VCH publisher, pp. 185 - 193.
- Oppermann, F. B., S. Pickartz and A. Steinbüchel. 1998. Biodegradation of polyamides. Polym. Degrad. Stabil. 59:337-344